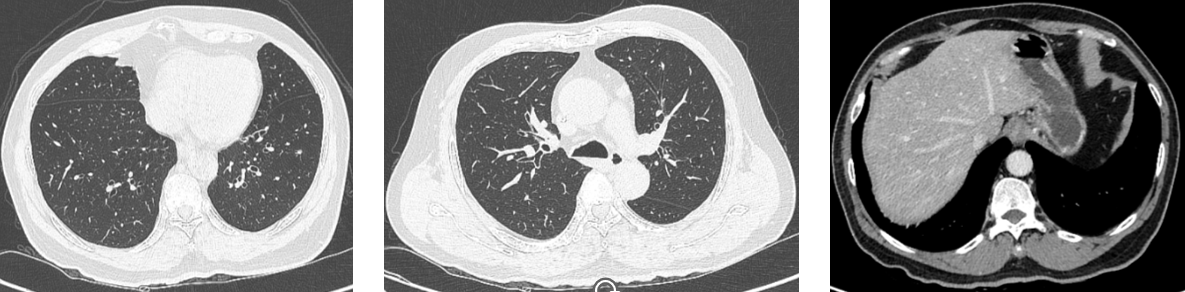

结直肠癌(CRC)是我国最常见的恶性肿瘤之一,近年来发病率呈明显上升趋势。尽管随着治疗手段的改进、新药物的使用以及分子分型的普及使得CRC患者的整体预后得到改善,但仍存在许多挑战。曲氟尿苷替匹嘧啶(TAS-102)是一种已经获批用于mCRC治疗的新型口服化疗药物,在晚期mCRC的治疗中发挥了重要作用。【肿瘤资讯】特邀彭雯教授、刘晨教授、王坚教授、程先硕教授、梁仁佩教授与王继伟教授,分享2例从TAS-102的治疗中获益的晚期CRC病例,供读者交流讨论。
病例一:
mCRC患者三线应用TAS-102+贝伐珠单抗,生存获益显著
病例汇报:彭雯教授 贵州省人民医院
病例点评:
刘晨教授 福建医科大学附属第一医院
王坚教授 楚雄州人民医院
贵州省人民医院肿瘤科
肿瘤学博士
中华结直肠癌MDT联盟贵州分盟贵阳分会常任委员兼秘书
四川省国际医学交流促进会消化道肿瘤专业委员会常务委员
中国肿瘤防治与科普分会委员
中国老年保健协会肿瘤免疫治疗专业委员会委员
贵州省中西医结合学会肿瘤专业委员会委员
贵州省中医药学会肿瘤专业委员会青年委员
四川省国际医学交流促进会精确放射治疗专业委员会委员
发表SCI论文十多篇,参与国家级课题一项,主持省级课题一项
病例介绍
1. 患者基本情况
一般资料:女,65岁。
现病史:2019年7月出现上腹部疼痛伴腹胀,呕吐,呃逆,便血,无大便次数增多,大便变细等不适,症状持续存在并逐渐加重。
既往史:慢性萎缩性胃炎病史。
家族史:父亲死于白血病。
查体:KPS 90分,浅表淋巴结(-),腹部无压痛、反跳痛。肛门指检:进指约6 cm未触及新生物,退出指套无血染。
辅助检查:(2019年10月,外省医院)肠镜:升结肠梗阻,病理明确为升结肠黏液性腺癌。
全腹部增强CT:1、肝内异常强化结节,转移可能;2、升结肠改变,考虑癌并系膜淋巴结转移可能。
肺部高分辨CT:右肺门软组织结节,考虑转移可能。右肺上、下叶及左肺散在实性、磨玻璃结节。
肝脏MRI : 升结肠癌,伴肝内多发占位,考虑转移。右肝囊肿,双肾囊肿。腹膜后淋巴结稍肿大。
初步诊断:
升结肠癌 肝、肺转移IV期。
2. 治疗经过
手术及一线治疗(外省医院):
2019年10月 因肠梗阻行“机器人姑息性右半结肠切除术+肠粘连松解术”。
术后病理:(右半结肠)中分化腺癌,肿瘤侵及肠周脂肪层,肿瘤浸润最深处据环周切缘距离<1 mm,另见2枚淋巴结均见癌转移;(近切缘,远切缘)未见癌组织,(肠系膜淋巴结)见癌转移(5/21),另见一枚癌结节。
免疫组化:MSH2(+)、MSH6(+)、MLH1(+)、PMS2(+)、Ki-67(90%)。
基因检测:EGFR、KRAS、NRAS、BRAF未见突变,HER2(-)。
术后替吉奥单药化疗一周期,6周期FOLFOX(奥沙利铂+氟尿嘧啶,Q2W)化疗,疗效评价不详。因为疫情就医不便,患者未继续规律治疗,间断口服卡培他滨单药化疗,最后一次化疗结束时间:2020年12月。
二线治疗:
2021年4月 全腹部CT增强+盆腔CT增强:1、结肠癌术后改变;2、肝内多发异常强化灶结合病史考虑转移瘤;3、左侧附件区占位,考虑转移瘤可能性大,盆腔少量积液。

肝脏MR增强+肝脏MR平扫:肝内多发异常强化灶结合病史考虑转移瘤(最大病灶32 mm*30 mm)。胆囊胆汁淤积/泥沙样小结石。

胸部CT增强扫描:右肺上叶前段小结节灶,随诊。左肺上叶前段、右肺下叶外基底段炎性灶。右肺上叶小钙化灶。主动脉硬化。

MDT讨论:诊断:升结肠腺癌 肝、肺转移原发灶姑息术后化疗后附件转移 IV期。治疗目标:转化治疗,争取达NED,治疗方案:化疗联合靶向治疗。
2021年4月至11月 共行12周期FOLFIRI(伊立替康+氟尿嘧啶)化疗+西妥昔单抗靶向治疗。期间复查全腹部增强CT+盆腔CT增强(2021年9月):肝内多发异常强化灶,病灶较前变小。 左侧附件区囊实性占位较前缩小。胸部CT增强扫描(2021年9月):右肺上叶前段小结节灶,较前相仿。病灶持续缩小,疗效评价部分缓解(PR)。


MDT讨论:具备手术条件,可行手术切除。患者及家属拒绝。伊利替康联合西妥昔单抗维持治疗。
2022年1月 全腹部增强CT+盆腔增强CT:结肠癌术后改变。 肝内多发异常强化灶,病灶较前强化明显,密度减低区较前缩小。 左侧附件区实性成分较前增多、增大,囊性成分较前缩小。
胸部CT增强扫描:较前未见明显变化。疗效评价疾病稳定(SD)。

2022年3月 腹腔镜下肝S6段、S8段肿瘤切除术,附件转移病灶切除术。术后病理提示肝S8段肝切缘局灶见癌,切缘阳性。
术后基因检测:APC、PIK3CA、SOX9、LRP1B、SMAD3、TP53突变;KRAS、NRAS、BRAF未见突变;微卫星稳定(MSS);TMB-H(突变负荷12.85 Muts/Mb)。
2022年4月 术后FOLFIRI(伊立替康+氟尿嘧啶)+西妥昔单抗1周期。
2022年5月至7月 行“肝脏S8段术区”放疗, 6000cGy/200cGy/30F。
2022年7月至10月 口服卡培他滨维持治疗。
三线治疗:
2022年11月 上腹部增强CT+盆腔CT增强:肝病变切除术后改变,术区积液较前吸收,肝内新增异常强化结节。右上腹腔肿大淋巴结,较前稍增大。结肠癌术后改变,吻合口局部肠壁梢增早,周围多发小淋巴结。
胸部CT增强扫描:右肺上叶小结节灶,较前未见明显变化。右肺中叶、下叶新增炎性灶,双肺少许纤维化灶;右肺上叶小钙化灶。
2022年11月至今 TAS-102+贝伐珠单抗靶向治疗。
3. 病例小结
该患者为老年女性,2019年10月诊断为升结肠癌 肝、肺转移IV期。患者依次经过外科手术、辅助化疗、三线系统抗肿瘤、放疗治疗,生存至今。在三线应用TAS-102+贝伐珠单抗期间,患者耐受性可,生存获益显著。

福建医科大学附属第一医院 肿瘤内科
擅长 各种恶性肿瘤的诊断及化疗、分子靶向治疗与免疫治疗。专病专长:结直肠癌,乳腺癌,肺癌,淋巴瘤
广州南方医科大学肿瘤学硕士,进修于广州中山大学肿瘤防治中心
福建抗癌协会心理学分会委员
福建抗癌协会康复分会委员
福建省中西医结合协会癌痛分会委员
从事肿瘤临床治疗多年,在国际发表肿瘤研究论文多篇,参与、主持包括国家自然科学基金、福建省自然科学基金、福建省卫健委科技计划项目在内的多项肿瘤研究课题。
楚雄州人民医院肿瘤科
云南省抗癌协会理事
云南省医师协会临床精准医疗委员会第一届委员会委员、常委
云南省医师协会肿瘤转化医学医师分会第二届委员会委员
云南省医学会肿瘤学分会第九届委员会青年委员会委员
云南省转化医学学会肿瘤转移分会第一届委员
刘晨教授:这是一例成功的晚期右半结肠癌转化治疗病例。本患者治疗思路规范,从手术、到多线的系统药物治疗都与指南相符合。患者初诊IV期,一线治疗时应及时进行分子检测,联合西妥昔单抗或贝伐珠单抗治疗。患者对西妥昔单抗反应较好,术后可西妥昔单抗维持治疗。患者依从性佳、多次MDT讨论为患者带来最大生存获益。
王坚教授:本例患者一线、二线、三线治疗规范,总生存(OS)已超过36个月,总体治疗结果令人满意。患者姑息术后应行基因检测,及时联用靶向治疗,争取为患者带来最大获益。患者转化治疗后达到NED,但术后较快又有新发肝转移病灶,不能除外术前已存在,可在术前行肝动脉造影,如不达NED状态,可考虑对肝转移病灶行经导管动脉栓塞(TACE)。
病例二:
四线PFS反超前线,TAS-102助力晚期CRC患者长生存
病例汇报:程先硕教授 云南省肿瘤医院
病例点评:
梁仁佩教授 中国人民解放军联勤保障队第910医院
王继伟教授 遵义医科大学附属医院
云南省肿瘤医院/昆明医科大学第三附属医院结直肠外科
云南省干细胞与再生医学协会第一届委员
云南省抗癌协会肿瘤药物临床研究专业委员会第一届委员
云南省医学会肿瘤学分会泛家族遗传性肿瘤防控学组秘书
云南省医学会外科学内分泌外科专业学组组员
擅长结直肠癌微创治疗;复发,转移性结直肠癌的综合诊治。
主持云南省省级项目2项,参与国家重点研发计划1项,国家自然科学基金3项,云南省科技厅重点项目3项,其他省级项目10项
WJGO, Cancer Investigation, Frontier in immunology,Frontier in oncology, PLOS one等杂志审稿人
《南方医科大学学报》特约审稿专家,2023年度优秀审稿专家
获得云南省科技进步奖一等奖1项,西山区科技进步奖二等奖1项
参编专著2部,译著1部,授权发明专利1项,申请发明专利4项,发表论文50余篇,其中,专家论坛1篇,SCI :16篇。
病例介绍
1. 患者基本情况
一般资料:男,63岁。
主诉:确诊直肠癌2年余。
现病史:患者2020年12月在外院行腹腔镜下乙状结肠癌根治术,术后病理乙状结肠中分化腺癌,肿瘤侵犯达浆膜层,淋巴结3/16转移,乙状结肠癌术后1月余。
查体:体温36.6℃,脉搏71次/分,血压99/61 mmHg,全身浅表淋巴结未触及肿大,心肺腹(-);肛门指检:距肛门口5 cm未触及异常。BMI 29.03 Kg/m2; ECOG PS评分:0分;营养风险评分(NRS) 1分;日常生活能力(ADL)I级。
既往史:无特殊。
个人史:吸烟史50余年、饮酒史。
家族史:1个妹妹患甲状腺癌。
辅助检查:CEA: 5.02 ug/L,CA242:8.26 Ku/L,CA19-9:9.71 Ku/L,CA125:30.81 KU/L。
(2021-01-12)胸腹部CT:1."乙状结肠恶性肿瘤术后":乙状结肠吻合口壁增厚伴周围间隙模糊,建议复查。2.双肺散在小结节;双肺散在小条索;建议复查。3.脂肪肝。左肾小囊肿。4.脑、胆囊、胰腺、脾脏、右肾及双侧肾上腺、膀胱、前列腺未见明显异常。5.纵隔、上中下腹腹膜后及盆腔内未见确切肿大淋巴结。
基因检测: KRAS野生,NRAS,BRAF未突变;VEGFR2 低表达;MSS型。
初步诊断:
乙状结肠中分化腺癌术后 pT3N1bM0。
2. 治疗经过:
一线治疗(外院):
2021年1至3月 行mFOFOX6方案化疗5周期(用药及剂量:L-OHP 150 mg,L-CF 0.3,5-FU 0.6,5-FU 4.25微量泵入46小时),奥沙利铂出现严重过敏。
2021年4月 更换FOLFIRI方案化疗,具体周期数和时间节点不明确(用药及剂量:CPT-11 320 mg,L-CF 0.3,5-FU 0.6,5-FU 4.25微量泵入46小时)。
术后复查CT:1、乙状结肠吻合口壁稍增厚;左下腹壁术后改变;上述较前变化不明显,请结合临床及复查。2、脂肪肝;肝右前叶下段小钙化斑;3、双肺纹理清晰,气管支气管通畅,未见狭窄或阻塞征。双肺见散在多个实性小结节影,大者位于右肺中叶内侧段近水平裂处,大小约0.5 cm×0.3 cm(肺窗薄层187),边界清晰。
2021年8月 术后辅助治疗后复查腹部CT:1、双肺多发小结节,部分较前稍增大;2、肝右后叶上段结节,较前新出现。双肺多发实性小结节,稍大者位于左肺下叶前内基底段,大小约0.9 cm×0.5 cm(肺窗薄层281,前片该结节直径约0.5 cm);左肺上叶尖后段厚壁透亮结节,大小约1.1 cm×0.9 cm(肺窗薄层156),粘连邻近肺小血管。
诊断:乙状结肠腺癌肝肺多发转移 MSS型 rpT3N1bM1b IVB期。

二线治疗:
2021年8月至2022年1月 行FOLFIRI+贝伐珠单抗方案化疗8周期(用药及剂量:CPT-11 320 mg,L-CF 0.3,5-FU 0.6,5-FU 4.25微量泵入46小时,贝伐珠单抗 400 mg静滴)。
2021年9月 行肝脏射频消融术。
PET/CT:1、结肠吻合口相邻肠系膜区及骶前肠系膜区代谢增高软组织灶,考虑为恶性(多为转移)。2、双肺多发结节状及环状密度增高灶,部分伴轻度代谢增高,考虑为转移。左肺散在炎性条索灶。3、肝右后叶上段类圆形低密度灶,未见代谢增高,多考虑病灶治疗后活性受抑。肝左外叶上段结节状代谢增高灶,多考虑为转移。




2022年2月 行“腹腔肿瘤切除术+腹腔灌注化疗术(洛铂60 mg)”。
2022年3月 腹见片状积气,范围约9.0 cm×2.7 cm。结合患者病史考虑肠梗阻,予以止痛及胃肠减压等对症处理,缓解。
2022年3月至5月 回当地进行治疗,未曾使用抗生素,等待入组临床研究。
2022年6月 双肺多发实性小结节,较大几个病灶约1.3 cm×0.8 cm(右肺下叶前基底段、肺窗薄层267)、1.2 cm×0.8 cm(左肺下叶前内基底段、肺窗薄层279)、0.6 cm×0.6 cm(右肺下叶后基底段、图324)、0.8 cm×0.5 cm(右肺上叶前段、薄层图141),病灶形态不规则;左肺上叶尖后段厚壁空腔结节,大小约1.4 cm×0.8 cm(肺窗薄层169),形态不规则,壁厚薄不均,粘连邻近肺小血管。

骶前区小片软组织密度灶,边界不清;紧邻上述病灶腹膜返折处见软组织结节,范围约1.3 cm×0.7 cm,强化欠均。膀胱左前方见范围约2.2 cm×1.3 cm软组织灶,增强后中等度强化,病灶粘连前腹壁及膀胱壁。

三线治疗:
2022年6月至8月 入组“粪菌胶囊+抗PD-1+贝伐珠单抗”临床研究。乙状结肠癌伴肝转移癌术后免疫联合靶向治疗5天,腹痛3天,阵发性绞痛,对症治疗后症状缓解,并出现小便带血。期间发生肠梗阻症状3次,考虑癌性梗阻,给对症支持治疗好转。
2022年10月 双肺多发实性小结节,较大几个病灶约1.9 cm×1.4 cm(右肺下叶前基底段、肺窗薄层221)、1.6 cm×1.3 cm(左肺上叶尖后段,肺窗薄层157),形态不规则,边缘见分叶及毛刺,病灶内见空泡,增强扫描不均匀强化,部分粘连邻近肺小血管。

肝脏边缘光滑;平扫肝实质密度减低,右前叶下段见点状致密影;肝右前叶上段可见一团片状低密度区,大小约4.2 cm×3.1 cm,增强未见确切强化;肝左外叶、右前叶下段见稍低密度结节影,大者位于左外叶,大小约2.5 cm×2.2 cm。

骶前区小片软组织密度灶,范围约5.0 cm×3.3 cm,边界不清;紧邻上述病灶腹膜返折处见软组织结节,范围约1.6 cm×0.9 cm,强化欠均。膀胱左前方见范围约2.5 cm×1.8 cm软组织灶,增强后中等度强化,病灶粘连前腹壁及膀胱壁。


四线治疗:
2022年11月至2023年4月 行“TAS-102联合贝伐珠单抗”6周期(用法用量:TAS-102 60 mg bid;贝伐珠单抗 5 mg/ kg)。发生不全性肠梗阻症状3次,考虑癌性梗阻,给对症支持治疗好转。2023年1月至4月未再发生不全性肠梗阻。


2023年4月至11月 行“TAS-102联合贝伐珠单抗”14周期(用法用量:TAS-102 60 mg bid;贝伐 5 mg/ kg),未再发生不全性肠梗阻;患者自诉症状缓解明显,毒副作用低。
2023年12月 双肺多发不规则结节,大者位于左肺上叶尖后段及右肺下叶前基底段,大小分别约1.7 cm×1.3 cm、1.6 cm×1.5 cm。

肝S7段可见一团片状低密度区,大小约4.3 cm×3.0 cm,增强扫描未见强化;肝内见多发稍低密度结节,边缘模糊,平扫边界不清,增强扫描欠均匀轻度强化,大者大小约0.9 cm×0.6 cm(S4段,新发)、3.3 cm×3.5 cm(S2段,较前增大)、1.4 cm×1.2 cm(S5段,新发)、0.6 cm×0.6 cm(S6段,新发)。

骶前区软组织灶,范围平扫密度不均,增强扫描欠均匀强化,边缘模糊,范围大致约4.3 cm×2.8 cm;乙状结肠吻合口壁增厚呈片状软组织灶,范围约4.1 cm×2.7 cm,与邻近小肠管壁粘连,并小肠壁增厚,周围脂肪间隙模糊;膀胱左前方见范围约3.3 cm×1.7 cm软组织灶,边界不清,病灶粘连膀胱壁。


后线治疗:
2023年12月至2024年1月 行“FOLFOX联合西妥昔单抗”2周期。第二次治疗期间再次出现奥沙利铂的严重过敏,停止奥沙利铂的输注。
2024年1月至3月 行“5FU联合西妥昔单抗”3周期。

2024年4月 在急诊下行开腹探查+复杂肠粘连松解术+膀胱底部肿瘤切除+腹腔腹膜种植结节切除+小肠肠段切除+大网膜肿瘤切除+小肠系膜肿瘤切除+小肠肠壁种植病灶切除+回肠造口远端封闭+回肠近端造口术+直肠远端封闭+近端结肠造口术。目前尚在恢复过程中。
3. 病例小结:
该患者为老年男性,诊断为乙状结肠中分化腺癌术后 pT3N1bM0 。患者在乙状结肠癌根治术后,依次接受标准的一线、二线、三线系统抗肿瘤治疗,介入治疗,但结果不尽如人意。四线治疗采用TAS-102联合贝伐珠单抗的联合方案,PFS达到13个月。目前行5FU联合西妥昔单抗治疗。

中国人民解放军联勤保障队第910医院 肿瘤内科
泉州市抗癌协会第一届免疫治疗专业委员会委员
泉州市中医药学会肿瘤分会第二届委员
福建省海峡医药卫生交流协会临床肿瘤学诊疗分会理事
华侨大学医学院讲师,从事肿瘤内科工作10余年,2016年至福建省肿瘤医院进修放疗,擅长各种实体肿瘤化疗、放疗、介入治疗、靶向治疗、免疫治疗。发表核心论文7篇。
遵义医科大学附属医院胃肠外科、日间手术/化疗病区
中国卫生经济学会日间医学经济与管理分会 理事
中华医学会肠外肠内营养学分会“世界营养日协作组”委员
中华医学会肠外肠内营养学分会“加速康复外科协作组”委员
中国医师协会外科医师分会“临床营养外科工作组”委员
中国民族医药学会外科分会 常务理事
贵州省微生物学会微生物组学专业委员会 委员
遵义市医学会外科学分会 委员
遵义市医学会肠外肠内营养学分会 委员
遵义市智力支边专家 顾问
《遵义医科大学学报》青年编委
主持国家自然科学基金、贵州省科技厅基础研究计划、遵义医科大学博士科研启动基金各1项,入选遵义医科大学未来人才“临床名医”培养计划,发表SCI及中文核心期刊论文多篇。
梁仁佩教授:该患者的诊疗过程规范,经过手术、基因检测、介入及多线治疗后,目前OS已达到3年。患者四线应用TAS-102联合贝伐珠单抗后治疗效果较好,且未再出现肠梗阻,肿瘤标志物明显下降,肿瘤负荷减小,生活质量提升。目前结直肠癌治疗进入靶免时代,合理排兵布阵、推行MDT帮助治疗获益最大化。
王继伟教授:该患者整体治疗规范,诊断分期以及治疗均遵循指南,取得了长时间生存获益。此外纳入患者参加临床试验,通过调节肠道菌群降低不良反应,积极采取措施改善患者生活质量。患者存在奥沙利铂严重过敏,而伊立替康不作为术后辅助化疗常规推荐,可预处理或尝试脱敏疗法。如果持续存在严重过敏,可尝试氟尿嘧啶单药、卡培他滨或洛铂替代奥沙利铂。全程监测NGS指导诊疗。后线治疗基于SUNLIGHT研究,此例患者也证实了TAS-102联合贝伐珠单抗的优异疗效。
总结
多学科全程管理,为mCRC患者保驾护航
肝脏是结直肠癌血行转移最主要的靶器官,约有15%~25%结直肠癌患者在确诊时即合并有肝转移,而另15%~25%的患者将在结直肠癌原发灶根治术后发生肝转移,其中绝大多数(80%~90%)的肝转移灶初始无法获得根治性切除。临床中应通过多学科团队(MDT)对结直肠癌肝转移(CCLM)患者进行全面的评估,个性化地制定治疗目标,开展相应的综合治疗,以预防CCLM的发生、提高肝转移灶手术切除率和5年生存率[1]。但对于同时存在其他组织和脏器转移,如肺转移、骨转移、腹腔淋巴结转移等,或肝转移灶为弥漫性病变的患者,其治疗目标则是通过合理排兵布阵,使患者在一二三线得到系统性治疗,最大限度地延长患者OS时间。
随着治疗手段的不断丰富,晚期结直肠癌推行MDT和全程管理模式变得尤为重要,即达到治疗目的的同时,保持良好生活质量。既往肠癌的治疗以化疗为主,患者不良反应较重、耐受性差,生活质量大幅下降,尤其经过一线、二线治疗后,体能储备和耐受性都有所降低,后线可用药物选择较少。随着瑞戈非尼、呋喹替尼、TAS-102等药物上市,mCRC患者迎来更多治疗选择。其中,TAS-102作为一种口服细胞毒药物,可以视为“升级版”的氟尿嘧啶,在其抑制胸苷酸合成酶作用干扰DNA合成的基础上,还可以磷酸化产物渗入DNA,替代胸腺嘧啶的作用而干扰DNA合成。在2023年公布的SUNLIGHT研究中[2],TAS-102联合贝伐珠单抗相较于TAS-102单药能够带来更长的生存获益,两组的中位OS分别为10.8个月和7.5个月(HR=0.61)。目前,TAS-102联合贝伐珠单抗的方案已获得了《中国临床肿瘤学会结直肠癌诊疗指南(2024版)》的I级推荐[3]。在此基础上,TAS-102是否能够联合抗血管的TKI类药物,如呋喹替尼或瑞戈非尼,目前也有研究正在积极尝试。如何在联合的基础上控制好患者的不良反应,是临床实践中关注的要点。
随着精准治疗和分子靶向药物的进步,结直肠癌的诊疗模式向多学科共同诊疗发展。外科、肿瘤内科、放疗科、影像科、介入科以及分子肿瘤等多学科共同参与,有助于制订最适合患者的诊疗方案。目前,结直肠癌的MDT诊疗理念和模式在国内正处于普及推广阶段,以中低位直肠癌、T4b期的结肠癌、结直肠癌肝转移/肺转移、复发性结直肠癌病人为诊疗对象的MDT诊疗模式已经见诸于大型综合医院和肿瘤医院。然而,其组织架构、组织形式以及规范化程度尚值得进一步提高[4]。
[1]中国结直肠癌肝转移诊断和综合治疗指南(2023版)
[2] 2023 ASCO Poster 2606.
[3] CSCO 结直肠癌诊疗指南(2024版)
[4] 中华医学会外科学分会结直肠外科学组. 结直肠癌多学科综合治疗协作组诊疗模式中国专家共识(2023版)[J]. 中国实用外科杂志,2024,44(1):1-16.
排版编辑:肿瘤资讯-SY






苏公网安备32059002004080号